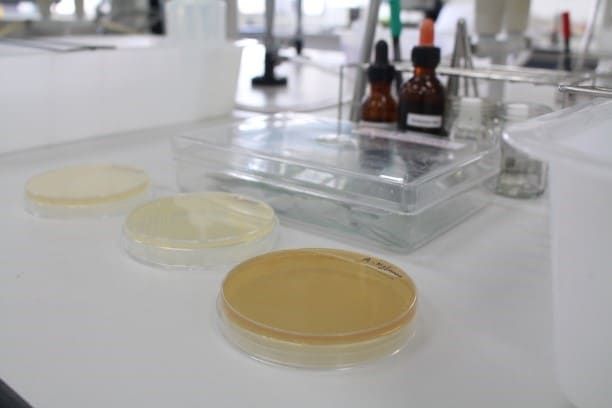

เทคโนโลยีชีวภาพอุตสาหกรรมมีบทบาทสำคัญต่อการพัฒนาเศรษฐกิจของประเทศ โดยเป็นกลจักรสำคัญในการขับเคลื่อนประเทศสู่การเปลี่ยนผ่านจากอุตสาหกรรมเดิม (First S-Curve) ไปสู่อุตสาหกรรมใหม่ (New S-Curve) ซึ่งเป็นอุตสาหกรรมที่มีความยั่งยืน มูลค่าสูง และเป็นมิตรต่อสิ่งแวดล้อม ในปัจจุบันการขยายตัวของการใช้ทรัพยากรชีวภาพเพื่อเพิ่มมูลค่าทางอุตสาหกรรมกำลังเกิดขึ้นอย่างรวดเร็ว และจำเป็นต้องใช้นักเทคโนโลยีชีวภาพอุตสาหกรรมที่มีความเชี่ยวชาญในด้านต่างๆ เช่น การแปรรูปอาหาร การเกษตร พันธุวิศวกรรม เป็นต้น นอกจากนี้เทคโนโลยีชีวภาพอุตสาหกรรมยังเป็นหนึ่งในปัจจัยที่ส่งเสริมความสามารถในการแข่งขันของประเทศในตลาดการค้าโลก ดังนั้นอุตสาหกรรมและเทคโนโลยีทางด้านนี้จึงได้รับการสนับสนุนเป็นอย่างดีโดยหน่วยงานภาครัฐและเอกชน บัณฑิตที่สำเร็จการศึกษาจากหลักสูตรเทคโนโลยีชีวภาพอุตสาหกรรมจึงเป็นที่ต้องการของตลาดแรงงานเป็นอย่างมากทั้งในปัจจุบันและอนาคต